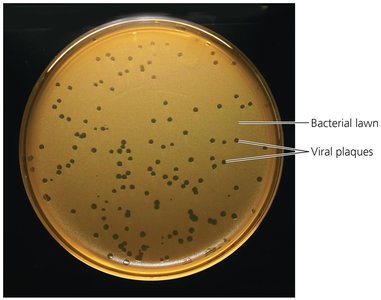
Viral plaques in a bacterial lawn

BackCharacterizing and Classifying Viruses, Viroids, and Prions
Study Guide - Smart Notes
Tailored notes based on your materials, expanded with key definitions, examples, and context.
Characterizing and Classifying Viruses, Viroids, and Prions
Viral Replication in Animal Viruses
Animal viruses replicate using a pathway similar to bacteriophages, but with key differences due to the presence of viral envelopes, the eukaryotic nature of animal cells, and the absence of a cell wall. The replication process involves several distinct steps:
Attachment: Animal viruses attach to host cells via chemical attraction between viral proteins (often glycoprotein spikes) and specific cell receptors. Unlike bacteriophages, animal viruses lack tails or tail fibers.
Entry and Uncoating: Animal viruses can enter host cells by three main mechanisms:
Direct Penetration: The viral capsid attaches and injects the genome into the cell, leaving the empty capsid outside.
Membrane Fusion: The viral envelope fuses with the host cell membrane, releasing the capsid into the cytoplasm.
Endocytosis: The host cell engulfs the virus in a vesicle, which is then uncoated to release the viral genome.

Synthesis: The strategy for viral genome replication and protein synthesis depends on the type of nucleic acid:
DNA viruses often replicate in the nucleus.
RNA viruses typically replicate in the cytoplasm.
Retroviruses use reverse transcriptase to make a DNA intermediate from their RNA genome, which is then integrated into the host genome.
Assembly and Release: Most DNA viruses assemble in the nucleus, while most RNA viruses assemble in the cytoplasm. Enveloped viruses acquire their envelope from the host membrane during release (budding), while naked viruses are released by exocytosis or cell lysis.

Comparison of Bacteriophage and Animal Virus Replication
The replication of bacteriophages and animal viruses shares some steps but differs in mechanisms of attachment, entry, uncoating, and release. The following table summarizes these differences:
Bacteriophage | Animal Virus | |
|---|---|---|
Attachment | Proteins on tail attach to proteins on cell wall | Spikes, capsids, or envelope proteins attach to proteins or glycoproteins on cell membrane |
Penetration | Genome is injected into cell or diffuses into cell | Capsid enters cell by direct penetration, fusion, or endocytosis |
Uncoating | None | Removed by cell or viral enzymes |
Site of Synthesis | In cytoplasm | RNA viruses in cytoplasm; most DNA viruses in nucleus |
Site of Assembly | In cytoplasm | RNA viruses in cytoplasm; most DNA viruses in nucleus |
Mechanism of Release | Lysis | Naked viruses: exocytosis or lysis; enveloped viruses: budding |
Nature of Chronic Infection | Lysogeny; always incorporated into host chromosome, may leave host chromosome | Latency, with or without incorporation into host DNA; incorporation is permanent |

Latency of Animal Viruses
Some animal viruses can remain dormant within host cells, a state known as latency. Latent viruses (or proviruses) may persist for years without causing symptoms. If the provirus integrates into the host DNA, the incorporation is permanent and may reactivate later.
The Role of Viruses in Cancer
Viruses can contribute to cancer development by disrupting normal cellular regulation. Protooncogenes are genes that promote cell growth and division; their uncontrolled activation (as oncogenes) can lead to cancer. Viruses may:
Carry oncogenes in their genomes
Activate host protooncogenes
Interfere with tumor suppressor genes
Examples of virus-associated cancers include Burkitt’s lymphoma, Hodgkin’s disease, Kaposi’s sarcoma, and cervical cancer.

Culturing Viruses in the Laboratory
Viruses require living cells for replication and cannot grow in standard microbiological media. Three main methods are used for culturing viruses:
Mature Organisms: Viruses can be grown in bacteria (as bacteriophages), plants, or animals. Plaque assays are used to estimate phage numbers by counting clear zones (plaques) on bacterial lawns.
Embryonated Eggs: Fertilized chicken eggs provide a sterile, nutrient-rich environment for viral growth and are used in vaccine production.

Cell Cultures: Viruses can be cultured in isolated animal or plant cells maintained in vitro.
Viroids: Infectious RNA Particles
Viroids are extremely small, circular, single-stranded RNA molecules that infect plants. They lack a protein capsid and do not code for proteins. Viroid RNA binds to complementary plant RNA, leading to degradation by plant enzymes and resulting in disease.

Prions: Infectious Proteins
Prions are infectious proteins that cause neurodegenerative diseases. Normal cellular prion protein (PrPC) has an α-helix structure, while the disease-causing prion form (PrPSc) has a β-pleated sheet structure. Prion PrP induces normal PrP to refold into the abnormal, pathogenic form.

Prion Diseases: Prions cause spongiform encephalopathies, characterized by vacuole formation in brain tissue, giving it a spongy appearance. Examples include BSE (mad cow disease), scrapie, kuru, chronic wasting disease (CWD), and variant Creutzfeldt-Jakob disease (vCJD).

Transmission: Prion diseases are transmitted by ingestion, transplantation, or contact with infected tissues. There is no standard treatment, and prions are resistant to normal sterilization but can be destroyed by incineration or autoclaving in concentrated sodium hydroxide.
Comparison of Viruses, Viroids, Prions, and Bacterial Cells
The following table summarizes the main differences among bacteria, viruses, viroids, and prions:
Bacteria | Viruses | Viroids | Prions | |
|---|---|---|---|---|
Width | 200–2000 nm | 10–400 nm | 2–10 nm | 5 nm |
Length | 200–500,000 nm | 10–400 nm | 50–400 nm | 5 nm |
Nucleic Acid | Both DNA and RNA | Either DNA or RNA, never both | RNA only | None |
Protein | Present | Present | Absent | Present |
Cellular | Yes | No | No | No |
Cytoplasmic Membrane | Present | Absent (some viruses have an envelope) | Absent | Absent |
Functional Ribosomes | Present | Absent | Absent | Absent |
Growth | Yes | No | No | No |
Self-Replicating | Yes | No | No | No, transforms PrP protein present in cell |
Responsiveness | Present | Some bacteriophages respond to host cell by injecting their genome | Absent | Absent |
Metabolism | Present | Absent | Absent | Absent |
